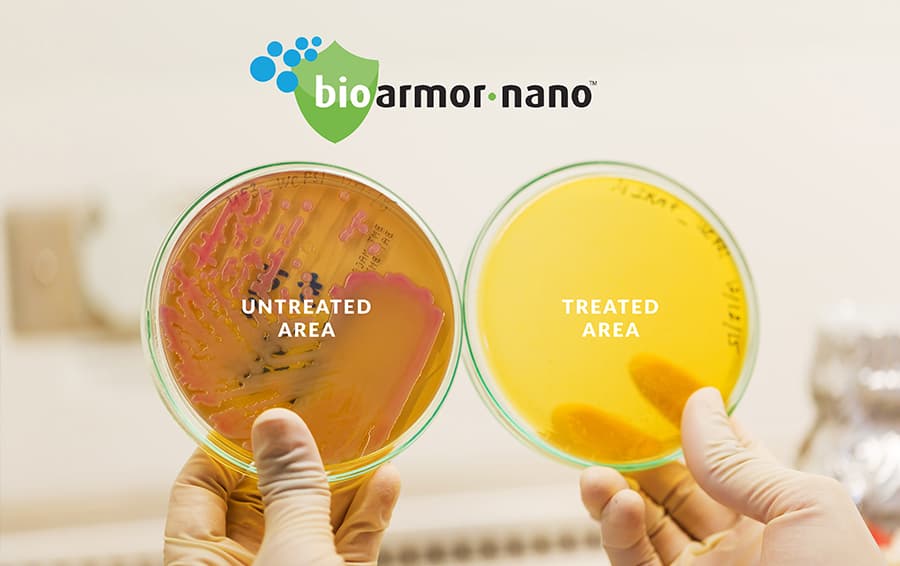

Bioarmor-nano® is a manufacturing company specialising in laboratory tested nano-thin, invisible protective surface coatings that were originally tested to give 99.9% reduction in surface microbes and bacteria, and we now have a 95% efficacy test result on an enveloped virus - after testing on the phi6 bacteriophage.
Bioarmor-nano® recently conducted a survey with over 200 people across the UK to find out more about the cleaning habits with the focus being on ‘antibacterial Vs. antiviral’. The survey results revealed that 58% of respondents prefer to purchase cleaning products that are both antibacterial and antiviral - meaning they protect their family home from harmful viruses and bacterias at the same time. When respondents were asked to ‘choose the three most important factors of purchasing cleaning sprays/wipes’, 57% chose ‘does what it says’, 54% chose ‘affordable’ and 53% chose ‘protects my home’.
Other results from the survey showed that when people hear or see the word ‘antiviral’ in regards to cleaning products they think of the words such as ‘protects’, ‘prevents’, ‘fights’ and ‘kills’.
When they hear or see the word ‘antibacterial’ in regards to cleaning products they think of the words such as ‘harmful bacterias’, ‘protects’, ‘prevents’ and ‘fights’.
John Shaw, Bioarmor European Director commented: “There’s a huge upsurge in interest of all of our products, and the need to protect surfaces in our homes, products, devices and offices from the effects of harmful bacterias that target surfaces. It’s important to mention that not all bacterias and microbes are harmful, but the importance of keeping our personal spaces clean and protected from harmful microbes is one result of what we have learned from the Coronavirus pandemic.
“Our products have been tested to ISO standards on the E-coli, MRSA and Staphylococcus aureus bacteria and we have now concluded successful testing on the phi6 virus in a controlled laboratory environment. The non-porous substrate treated with Bioarmor-nano® demonstrated a reduction of up to 95% of the phi6 enveloped virus after contact with it for 24 hours.
We are now in the process of negotiating with several high protocol level labs to test on the actual Coronavirus, and will update the nation as soon as we have any further exciting news for protecting their important surfaces.”